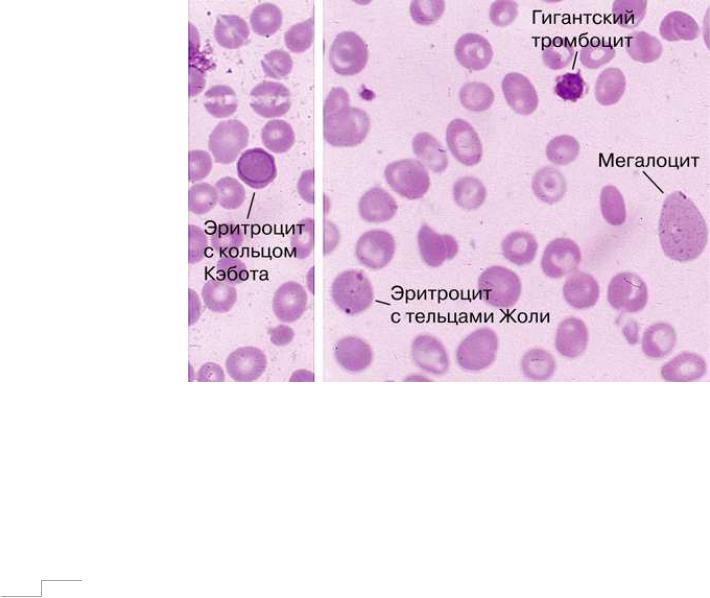

Материал: blood4

IV. Гиперхромные анемии
К гиперхромным анемиям относят состояния, при которых сниженное количество эритроцитов и гемоглобина сочетается с повышенным уровнем цветного показателя эритроцитов (более 1,05). Представителями анемий этой группы являются В12-дефицитная анемия и фолиеводефицитная анемия.
IV.1 В12-дефицитная анемия
Витамин В12, или иначе – кобаламин, представляет собой соединение,
содержащее в своем составе кобальт, и является необходимым фактором метаболизма нуклеиновых кислот и миелина в организме. Известно, что вырабатываемый слизистой желудка гастромукопротеин (внутренний фактор Касла) обеспечивает всасывание витамина В12 (внешний фактор) в
кишечнике посредством образования с ним специфического комплекса.
Поскольку витамин В12 необходим для нормального метаболизма нуклеиновых кислот в организме целом, и при созревании клеток крови, в
частности, то очевидно, что нарушение какого-либо процесса на этапе утилизации кобаламина приводит к развитию нарушения кроветворения – возникает анемия, нередко сопровождающаяся лейкопенией и тромбоцитопенией. При этом среди наиболее часто встречающихся причин развитиядефицита витамина В12 выделяют:
∙Нарушение адекватной работы слизистой желудка, когда образования комплекса «витамин В12 – фактор Касла» не происходит, ввиду этого становится невозможным транспорт кобаламина из просвета кишки в клетку. Отсутствие гастромукопротеина является самой частой причиной развития В12-дефицитной анемии и всегда возникает в случаях оперированного желудка и развития атрофической гастропатии,
возникающей при активизации аутоиммунных процессов, а также на фоне алкоголизма.
70

∙Повышенная потребность организма в витамине В12.
Естественным образом это встречается при беременности и лактации. Тем не менее, ряд патологических состояний так же способен вызвать нехватку витамина В12 – например, дисбиоз кишечника с повышенным потреблением кобаламина патологическим очагом и патогенной микрофлорой, наличие глистных инвазий, в особенности широкого лентеца, конкурентно поглощающего кобаламин в больших количествах.
∙Приверженность вегетарианству и отсутствие в рационе продуктов,
богатых витамин В12 (мясо, яйца, молоко, сыр, субпродукты,
бобовые) вызывает алиментарный дефицит витамина В12.
∙Наличие врожденной патологии ферментных систем, участвующих в реакциях транспорта и утилизации витамина В12, наблюдаемое,
однако, крайне редко.
∙ Нарушения процессов кишечного всасывания, возникающие при синдроме мальабсорбции, неспецифических язвенных заболеваниях кишечника, резекции кишечника, также называются серди причин дефицита витамина В12, однако следует подчеркнуть,
что дебют анемии в данном случае будет носить нормохромный характер, поскольку при указанных состояниях нарушается всасывание всех питательных веществ, а не избирательно витамина В12. В случае, если на каком-либо этапе дефицит витамина В12
перейдет на лидирующие позиции – может возникнуть картина в12-
дефицитной анемии.
Следует отметить, что первая причина из приведенного списка является самой распространённой на практике. При этом В12-дефицитная анемия развивается через 2-4 года после нарушения процессов усвоения кобаламина.
Связано это с тем, что печень запасает большое количество витамина В12, и
истощение этого депо происходит в течение нескольких лет, сопровождаясь
71

появлением и постепенным нарастанием соответствующей клинической картины.
Проявления описываемой нозологии, наряду с типичным анемическим синдромом, представлены специфической неврологической симптоматикой,
получившей название фуникулярного миелоза. Клиническими проявлениями фуникулярного миелоза являются:
∙признаки периферической полинейропатии – парастезии, ватные ноги, ощущение зябкости, онемения конечностей, могут присоединяться парезы и параличи, нарушение глубокой чувствительности, нарушение функции тазовых органов, появляется атаксическая походка;
∙трансформация слизистой оболочки языка – язык становится малинового цвета, а в случае атрофии сосочков – приобретает
«лакированную» поверхность (глоссит), возникает нарушение вкуса;
∙признаки психических нарушений – эмоциональная лабильность,
депрессия, нарушение памяти, ориентации в пространстве,
возможно возникновение органических психозов с галлюцинациями.
Патогенез развития фуникулярного миелоза связан с токсичеким воздействием на нервные клетки метилмалоновой кислоты. Последняя в повышенном количестве образуется при несовершенном процессе метаболизма жирных кислот с нечетным количеством углеродных атомов, где необходим кофермент витамина В 12 – дезоксиаденозилкобаламин. При дефиците этого вещества не происходит перехода метилмалоновой кислоты,
являющейся промежуточным соединением процесса распада указанных жирных кислот, в янтарную. В результате, метилмалоновая кислота накапливается и оказывает токсическое действие на нервные клетки.
72

Одновременно с процессом распада страдает и синтез жирных кислот с нечетным числом углеродных атомов. Поскольку эти соединения входят в состав миелина, то при их нехватке нарушается его структура – происходит демиелинизация нервного волокна. Указанные процессы в совокупности объясняют возникновение периферической неврологической симптоматики в рамках фуникулярного миелоза.
Что касается нарушений высшей нервной деятельности при недостатке витамина В 12, то патогенез этих состояний принято связывать не с патологическим обменом жирных кислот, а скорее с глубокой гипоксией головного мозга на этом фоне.
Как известно, присоединение признаков фуникулярного миелоза происходит, как правило, при В12-дефицитной анемии средней или тяжелой степени, поэтому следует особо внимательно относиться к жалобам со стороны нервной системы у больных с подозрением на В12-дефицитную анемию. Зачастую, узнать об имеющихся признаках фуникулярного миелоза можно только при тщательном, целенаправленном опросе. Это связано с тем,
что В12-дефицитная анемия и фуникулярный миелоз развиваются наиболее часто у пациентов пожилого возраста, когда полинейропатия может являться следствием ряда причин, и истинный ее генез бывает трудно выявить. Между тем, верификация фуникулярного миелоза у больных с гиперхромной гипорегенераторной анемией необходима для проведения дифференциальной диагностики В12- и фолиеводефицитной анемии, особенно в тех случаях,
когда доказать то или иное заболевание биохимическими методами не представляется возможным. Сочетание гиперхромной гипорегенераторной анемии с фуникулярным миелозом не оставляет сомнений в диагнозе В12-
дефицитной анемии.
Описываемая клиническая картина достаточно специфична, и в случае развернутых проявлений болезни не оставляет вопросов при постановке диагноза В12-дефицитной анемии. Тем не менее, исследование периферической крови всегда необходимо. При анализе гемограммы наряду с
73
гиперхромной гипорегенераторной анемией различной степени тяжести определяется морфологически измененные эритроциты - макроциты и мегалоциты, с патологическими включениями в форме телец Жолли и колец Кебота (рис. 17). Указанные структуры представляют собой терминальные ядерные элементы в клетке. Помимо этого возможно обнаружение специфической базофильной пунктуации эритроцитов, возникающей в результате гиперпродукции РНК. Что касается других элементов крови, то изменения их вариабельны. Нередко встречается снижение количества нейтрофилов, которые при этом приобретают увеличенные размеры и гиперсегментоядерность. Существуют клинические наблюдения агранулоцитоза на фоне В12-дефицитной анемии, однако они достаточно редки. Тромбоцитарный росток повреждается в меньшей степени, поэтому регистрируемая тромбоцитопения, как правило, не проявляется клинически.
Рисунок 17. Мазок периферической крови при В12-дефицитной анемии.
Исследование костного мозга при В12-дефицитной анемии необходимо не только для подтверждения диагноза в случаях смазанной клинической
74